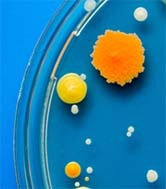
Bacteria in a petri dish against a blue background.

Our fully funded flagship PhD programmes.
These programmes and studentships offer specialist interdisciplinary projects and cover tuition fees, research costs and an annual stipend.
Many of them are linked to research councils and industry partners, and offer bespoke training and development, placements and international collaborations that enhance and enrich your research experience.
Explore each of our funded programmes to find out more.
On this page:
Related pages:
-

Kennedy Trust IMPACT Inflammation MB-PhD
Combine the vocational training of a medical degree with the research expertise of a PhD with our fully funded Kennedy Trust IMPACT Inflammation MB-PhD. Specialise in inflammation sciences and immunology research, and prepare for a future career in clinical research.
More about the Kennedy Trust IMPACT Inflammation MB-PhD
-

BBSRC North West Doctoral Programme in Bioscience
Become an interdisciplinary bioscientist of tomorrow with our fully funded Biotechnology and Biological Sciences Research Council (BBSRC) Northwest Doctoral (NWD) Programme in Bioscience. Explore cutting-edge postgraduate research opportunities across biotechnology, genomics and biological sciences.
More about our BBSRC NWDP in Bioscience studentships
-

MRC Doctoral Training Partnership
Shape the future of medical and healthcare sciences with our fully funded Medical Research Council (MRC) Doctoral Training Partnership (DTP). Engage in research to address key priorities across biomedical, clinical and health service areas and fulfil healthcare needs in the UK and across the world.
More about MRC DTP studentships
-

Excellence in Diversity PhD Scholarships
Fully funded scholarships for UK candidates from groups under-represented in postgraduate research.
More about the Excellence in Diversity scholarships
-

Bicentenary PhD Studentships and Fellowships
Pioneer the future of innovation and discovery at Manchester with our prestigious, fully funded Bicentenary PhD Studentships and Fellowships. Join us in celebrating our bicentenary and contribute to innovative scientific advancements across biology, medicine and health.
More about Bicentenary PhD Studentships and Fellowships
-

President's Doctoral Scholar Award
The University's flagship funding initiative giving outstanding home and international students the opportunity to undertake innovative interdisciplinary research across the University's faculties.
More about the President's Doctoral Scholar awards
-

PhD by Enterprise
Address global challenges such as climate change, health and inequality with our four‑year doctoral programme that combines world‑class research with structured entrepreneurship training.
More about the PhD by enterprise
-

International Partnership PhD Studentships
Expand your horizons with a global research opportunity through our fully funded International Partnership PhD Studentships. Undertake your PhD in an area of biology, medicine, and health at Manchester and spend time researching at one of our international partner institutions.
More about our International Partnership PhD studentships
-

Dual-award with the University of Melbourne
Broaden your horizons and gain a global perspective on your field with our fully funded Dual-award with the University of Melbourne. Benefit from world-class facilities, research expertise and leading academics at both universities.
More about the Dual award with the University of Melbourne
-

Joint scholarships with the China Scholarship Council (CSC)
Scholarships for Chinese PhD students through a joint scheme between the University and the CSC.
More about joint scholarships with the CSC
-

Alzheimer's Society Doctoral Training Centre
Join the next generation of dementia researchers with our fully funded Alzheimer's Society Doctoral Training Centre (DTC). Contribute vital research to find new treatments and approaches to tackle neurodegenerative diseases and dementia, and help improve the lives of those affected.
More about the Alzheimer's Society Doctoral Training Centre
-

CODE-M PhD Programme
Train to become a microbial bioengineer of the future with our fully funded CODE-M PhD Programme for home-fee eligible applicants, which includes an enhanced £31k tax-free, annual stipend.
More about the CODE-M PhD programme
-

MRC CoRE in Exposome Immunology PhD Studentships
Explore how environmental exposures influence immune responses with our fully funded Medical Research Council (MRC) Centre of Research Excellence (CoRE) in Exposome Immunology PhD studentships. Train across Manchester and Oxford within a research cohort tackling inflammation and immune-related disease.
More about the MRC CoRE in Exposome Immunology PhD Studentships
-

Cancer Research UK Manchester Centre PhD Training Scheme
Develop a career in world-leading cancer research through our fully funded clinical and non-clinical Cancer Research UK (CRUK) Manchester Centre PhD Training Scheme. Join a vibrant research environment, benefit from world-class cancer research facilities, and much more.
More about the Cancer Research UK Manchester Centre PhD Training Scheme
-

Cancer Research UK Manchester Centre MB-PhD
Combine the vocational training of a medical degree with the research expertise of a PhD through our fully funded Cancer Research UK (CRUK) Manchester Centre MB-PhD. Drive new innovations in cancer research and advance your career in oncology and cancer research.
More about the Cancer Research UK Manchester Centre MB-PhD
-

Cancer Research UK Manchester Institute PhD Studentships
Launch your career in basic, translational and clinical cancer research with our Cancer Research UK Manchester Institute PhD Studentships. Immerse yourself in cutting-edge, innovate cancer research and conduct multidisciplinary research in any area from across the whole spectrum of cancer research.
More about the Cancer Research UK Manchester Institute 4-year PhD studentships
-

EPSRC Doctoral Training Partnership
Tackle scientific and technological healthcare challenges with our fully funded Engineering and Physical Sciences Research Council (EPSRC) Doctoral Training Partnership (DTP). Develop the knowledge, experience, and skills required to address future challenges across biology, medicine and health areas.
More about the EPSRC DTP programme
-

ESRC North West Social Science Doctoral Training Partnership
The Economic and Social Research Council (ESRC) North West Social Science (NWSS) Doctoral Training Partnership (DTP) provides fully funded postgraduate research studentships across psychology, health and wellbeing, and social studies of science, technology and medicine.
More about the ESRC North West Social Science DTP
-

4Ward North PhD Programme for Health Professionals
Advance your clinical academic career with the fully funded 4WardNorth Clinical PhD Academy. This prestigious programme supports outstanding nurses, midwives, pharmacists, allied healthcare professionals and healthcare scientists to develop as future leaders in clinical research.
More about the 4Ward North PhD Programme for Health Professionals
-

British Heart Foundation Multidisciplinary PhD Programme
Drive innovation for the prevention and treatment of heart and brain disease with our fully funded British Heart Foundation PhD programme.
More about the BHF Multidisciplinary PhD Programme
-

British Heart Foundation Centre of Research Excellence Studentships
Train to be a competitive scientist in highly challenging and uniquely exciting interdisciplinary cardiovascular research environments through our fully funded British Heart Foundation (BHF) Centre of Research Excellence Studentships.
More about the BHF CRE programme
-

British Heart Foundation 4-year PhD programme
Contribute to pioneering research in heart disease and cardiology with our fully funded British Heart Foundation (BHF) PhD programme. Receive tailored doctoral training through a one-year MRes in cardiovascular sciences before choosing a research project in areas like cell signalling, human genetics, informatics, and bioengineering.
More about the BHF 4-year PhD programme
-

AI CDT in Decision Making for Complex Systems
Led by our Faculty of Science and Engineering, the AI Centre for Doctoral Training (CDT) in Decision Making for Complex Systems is training the next generation of AI researchers. Specialise in artificial intelligence, machine learning, and complex systems, and develop AI methods designed to accelerate new scientific discoveries.
More about the AI CDT in Decision Making for Complex Systems







.jpg)